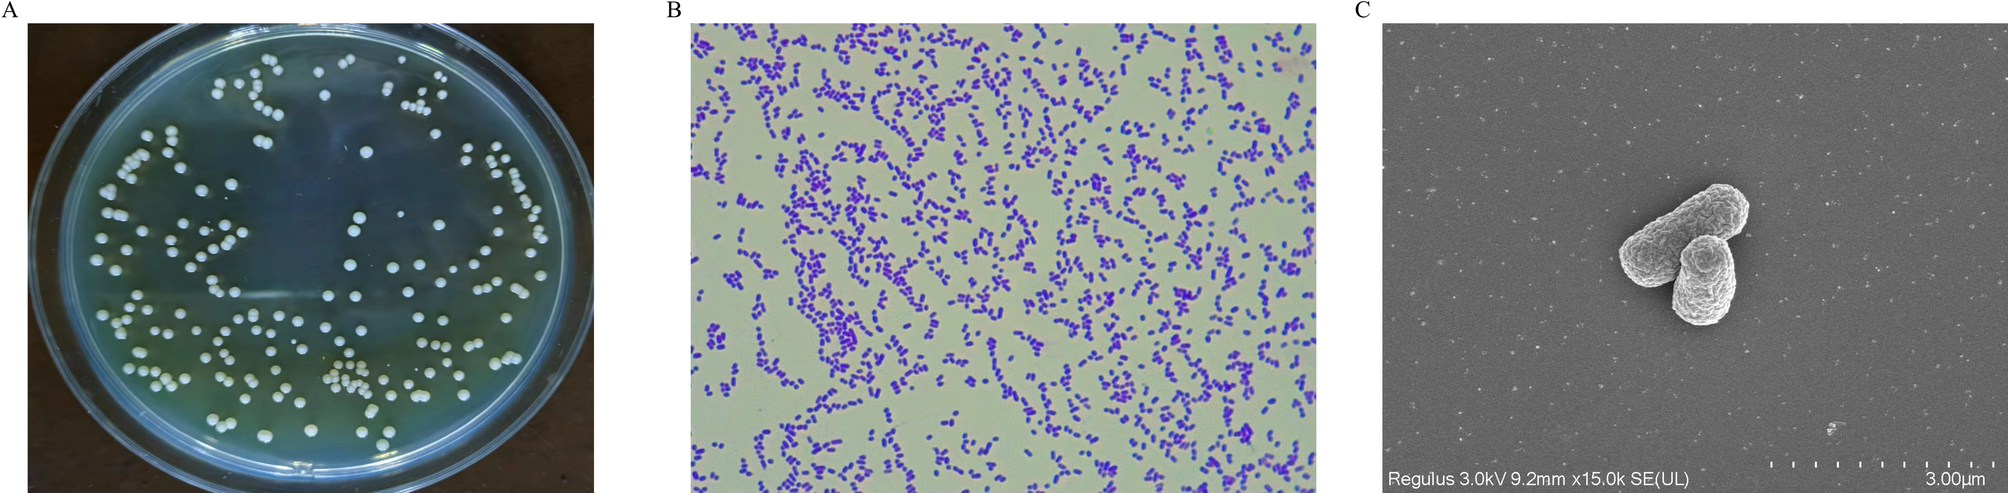
Fig. 1

Fig. 1

Morphological characteristics of the screened strain T2L. (A) Colony morphology. (B) Gram staining results. (C) Scanning electron microscopy results.
Morphological characteristics of the screened strain T2L. (A) Colony morphology. (B) Gram staining results. (C) Scanning electron microscopy results.